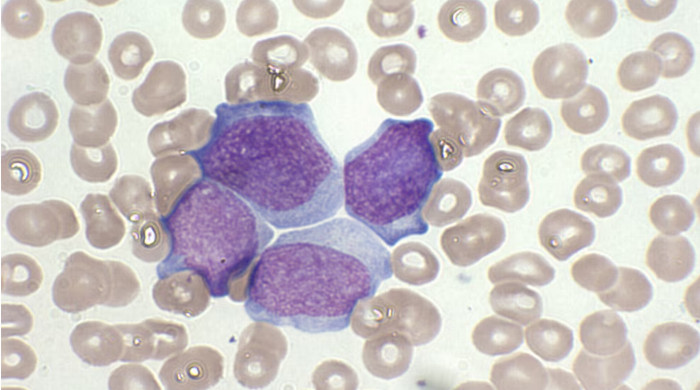

Santa Fe consolida su liderazgo logístico: más de 1,2 millones de toneladas y 860 operaciones en el primer trimestre de 2026
La Provincia alcanzó cifras históricas en el movimiento de cargas en puertos y aeropuertos, fortaleciendo

Ya son más de 600 las amenazas de tiroteos en escuelas: investigan un desafío en TikTok
Los avisos encendieron la alarma en el sistema educativo y de seguridad. Durante las últimas

Transferencia de rutas nacionales: Pullaro espera más definiciones sobre la A012
El gobernador santafesino pidió “mucha cautela” por el decreto que publicó el Gobierno nacional. Entendió

Taty Almeida recibió el doctorado honoris causa en la UBA: “Le demostramos a Milei que la resistencia continúa”
La presidenta de Madres de Plaza de Mayo -Línea Fundadora fue distinguida en la Facultad

Se vendió el avión decomisado: Santa Fe recaudó $1.564 millones en la quinta subasta
La jornada dejó una imagen difícil de olvidar: un salón colmado, paletas en alto, pujas

Milei habilitó a Santa Fe a administrar rutas nacionales con concesiones y peajes: ya hay un plan para la A012
El Poder Ejecutivo delega en la provincia la facultad de licitar, adjudicar y administrar tramos

Pullaro: “Santa Fe persigue el delito, encarcela a los delincuentes y les subasta los bienes para que vuelvan a víctimas e instituciones”
En el Salón Metropolitano de Rosario, el gobernador santafesino destacó que las subastas de bienes

Intendentes preparan una denuncia contra Luis Caputo por malversación de fondos públicos
Acusan al ministro de redirigir fondos del impuesto a los combustibles al circuito financiero. Con

Invierno 2026: el Aeropuerto de Rosario refuerza su conectividad con 8 vuelos semanales a destinos clave
Desde julio, el Aeropuerto Internacional de Rosario amplía su red aérea con vuelos directos a
Cambió el paradigma de tratamiento de la leucemia y logran resultados inéditos
La leucemia linfocítica crónica (LLC) es la más frecuente en adultos, se trata de un cáncer

Carne de burro en el país de las vacas donde comer asado es un lujo
Productores impulsan la faena de burro. En medio de la caída del consumo de carne

Milei concretó el desguace del INTI y ahora los privados autocontrolarán sus productos
El Gobierno resolvió que el Instituto Nacional de Tecnología Industrial abandone sus más de mil

SanCor pidió su propia quiebra: deuda millonaria, caída productiva y conflicto con trabajadores
La histórica cooperativa láctea formalizó el pedido de quiebra tras reconocer su imposibilidad de afrontar

Telepase y pago electrónico en el puente Rosario-Victoria: tras las pruebas, empezó a funcionar el nuevo sistema
La concesionaria Conexión Alto Delta SA había anunciado el cobro del pase entre ciudades desde

AUDIO: Audiencia Pública por la Red de Gas Natural en Pavón Arriba
Se llevó a cabo la audiencia pública donde se presentó el plan de la red

Ver fútbol en vivo por TV, una misión casi imposible: cinco plataformas y dudas para el Mundial
Argentina es un país futbolero por excelencia. Los cinco millones de personas en la calle

Territorio 5.0: Provincia adjudicó la implementación de videovigilancia con IA en la ciudad de Santa Fe
Se trata de una inversión de US$ 32 millones. Significará la llegada del sistema Lince

La inflación de marzo fue del 3,4%, y resultó la mayor en 12 meses
La inflación de marzo informó este martes el Instituto Nacional de Estadísticas y Censos (Indec) y acumuló un alza